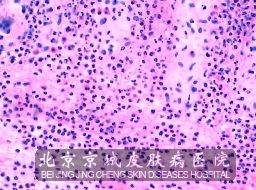

北京京城皮肤医院提供网络预约挂号服务
预约挂号热线:010-64888999
 三级专科
三级专科
 医保定点
医保定点
 舒适环境
舒适环境
 无假日
无假日
引发接触性皮炎的途径有哪些?容易引发接触性皮炎的物质有哪些?下面请我们北京京城皮肤医院皮肤病专家王家璧教授、殷致宇教授、吴大卫主任给大家解析一下引发接触性皮炎的途径有哪些吧,了解引发接触性皮炎的途径有哪些以后,在生活中一定要对这些有所避讳,减少接触性皮炎发生的几率。
北京京城皮肤医院皮肤病介绍,能使皮肤产生接触性皮炎的物质,通常都包括首饰、表链、镜架、凉鞋、化纤布料、外用药、化学品、化妆品等,一旦发现红肿、脱皮等现象出现,就要停止接触该过敏物质,并及时到医院做一下过敏原测试,听从医生的建议,及时进行治疗。
北京京城皮肤医院提醒各位患者,如想了解更多其他相关信息,您可以阅读本站其他文章,能够帮助您了解更多的这方面信息,想要节省您的阅读时间,也可以直接预约我们预约专家,预约专家将为您提供专业、详细的服务。还可以拨打挂号热线010-64888999或010-64888999 ,专家会针对您的具体问题进行详细服务的。
推荐阅读: